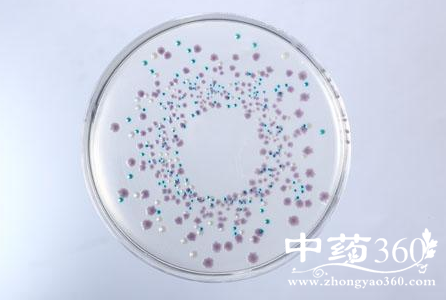

6种水果样品菌落值较高 大肠菌群过高有何危害
切块水果放一天还卖
近日,记者在西城区南礼士路、朝阳区广和东街、海淀区一所高校等地的水果超市,分别购买了6种盒装切块水果样品。
问及水果切开的时间,南礼士路和广和东街的两家水果店主均表示是刚切的新鲜水果,距销售时间不超2小时。同时,一所高校内两家水果店店主则表示,水果是当天切的,都很新鲜。
不过,其中一家水果店店主透露,有时上午切好的几十盒水果拼盘卖不完,就会留到下午一起卖,最长可能会放置一整天。
盒装水果大肠菌群高
记者将购买的6种盒装切块水果样品送至北京一家食品安全一级实验室,请实验人员模拟日常存储环境,分别检测样品的菌落总数和大肠菌群情况。记者还购买了新鲜西瓜,切两半分别通过有保鲜膜和无保鲜膜冷藏,一同送检。
实验结果显示,6种盒装水果样品的大肠菌群均大于等于24000mpn/100g,菌落总数从13000cfu/g到504000cfu/g不等。同时,无保鲜膜的冷藏西瓜样品的大肠菌群明显多于有保鲜膜的西瓜,菌落总数则多出20多倍。
目前,我国对新鲜水果菌落数量并没有相关的国家标准,但对水果制品的规定为菌落总数不得超过1000cfu/g,大肠菌群不超过30mpn/100g。
专家表示,水果中的菌落总数和大肠菌群量过高,如果体质不好,吃完很容易闹肚子生病。如果买盒装水果,尽量买刚切的,买回来最好立即吃。
■ 实验
实验地点:北京一家食品安全一级实验室
实验样品:通过水果超市、高校水果店等渠道购买6种盒装切块水果样品,并购买一个新鲜西瓜切成两半,分别通过有保鲜膜和无保鲜膜冷藏
实验过程:(检测菌落数量)将6份盒装切块样品分别称取各两份25g样品,将一份25g样品放入盛有225mL稀释液的无菌生理盐水中,再将6 份样品分 别制成1:100和1:1000的样品匀液。将两种不同浓度的溶液样品分别放置培养基中,常温下培养菌落24小时以上。
(检测大肠菌 群数量)将另外一份25g样品放入盛有225mL稀释液的无菌生理盐水中,分别制成样品匀液,采用9管法检测大肠菌群,将2种样品匀液分别放入9管乳糖胆 盐培养基,36℃恒温条件下培养24小时以上。如有试管中发生化学反应,再放入伊红美蓝培养基,36℃恒温下培养24小时以上。根据实验变化,最后再放在 乳糖培养基中培养24小时,最终检测大肠菌群。
同时,分别称取有保鲜膜冷藏和无保鲜膜冷藏的西瓜样品各两份,分别制成1:1000和1:10000的样品匀液。与上述方法相同,分别检测菌落总数和大肠菌群。
■ 实验结果
6种水果样品菌落值较高
实验显示,6种水果样品的大肠菌群均大于等于24000mpn/100g。同时,6种水果样品的菌落总数分别是128000cfu/g、228000cfu/g、504000cfu/g、13000cfu/g、43000cfu/g和47000cfu/g。
实验技术人员介绍,关于新鲜水果,目前并没有相关的国家标准,而且由于食用时间、存储环境不同,新鲜的切块水果的菌落标准难以统一。但从本次检测结果来看,6种盒装切块水果样品的菌落值都较高。
用保鲜膜比不用菌落少
结果显示,有保鲜膜冷藏的西瓜未检出大肠菌群;无保鲜膜冷藏的半块西瓜的大肠菌群是160mpn/100g。同时,无保鲜膜冷藏的西瓜菌落总数为20000cfu/g,是有保鲜膜西瓜样品菌落总数的20多倍。
实验技术人员介绍,夏日气温较高,新鲜切开的西瓜滋生细菌量较高,因此检测采用的是10的3次方和4次方来检测。实验结果表明,保鲜膜还是能够防止细菌滋生。
释疑1 水果切开后能抗菌多久?
中国农业大学食品学院营养与食品安全系副教授范志红表示,完整的蔬菜和水果的外皮均有一定的保护作用,有一定的抗菌能力。而蔬果离开土壤,而且被切开后,表面就容易细菌增殖。
实际上,各类水果切开后滋生细菌的情况因环境而异。一般情况下,温度越高越容易滋生细菌。同时,也与水果被切开时的环境有关,例如刀具是否干净。
此外,也与水果本身的特质有关,例如柠檬较酸、苹果质密且有酸性,都有一定的抑菌作用;而西瓜的抑菌作用较差,夏天在常温条件2到3小时就容易滋生大量细菌。
范志红建议,如果要购买盒装水果,尽量买刚切的,买回来最好立即吃,或者及时冷藏。
释疑2 冷藏到底用不用保鲜膜?
根据本次实验的结果,冷藏的有保鲜膜的西瓜样品中的菌落总数和大肠菌群明显少于无保鲜膜的样品。
但此前也有消息称“切开的西瓜盖保鲜膜还不如不用”。对此,范志红表示,这个结论有一定道理,因为在冰箱冷藏时,盖上保鲜膜在冰箱里降温慢,容易滋生细菌;而不盖保鲜膜,降温快,细菌滋生较少。
但实际上,此前实验结果的两种西瓜菌落差异并不大。同时,这种结论也有一定值得推敲的地方,测出有保鲜膜的西瓜反而细菌多,有可能是保鲜膜本身有细菌, 或者冷藏时冰箱内部有一定细菌会导致交叉污染。同时也跟放置的室温环境有关,如果是切开后先放在室温环境下再冷藏,容易先滋生细菌。这些都会影响检测结 果。
范志红建议,切开的西瓜需要冷藏时,最好还是盖上保鲜膜。这样一是能够避免西瓜与其他食物的交叉污染,二是防止冰箱内的细菌,尽量减少其他方面的污染。
释疑3 大肠菌群过高有何危害?
范志红介绍,细菌不等于致病菌,实际上90%以上的菌落都不致病。但是如果水果中的菌落总数和大肠菌群量过高,很难避免其中含有致病菌。尤其是大肠菌群,其中可能存在致病菌的概率更高。
水果中大肠菌群和菌落是否会致病,也因每个人的体质而异。一般胃酸比较多的人群,消化能力强、胃部杀菌能力也较强,不易生病;而老人、小孩和胃酸较少的人群,食用放置太久的水果很容易闹肚子生病。